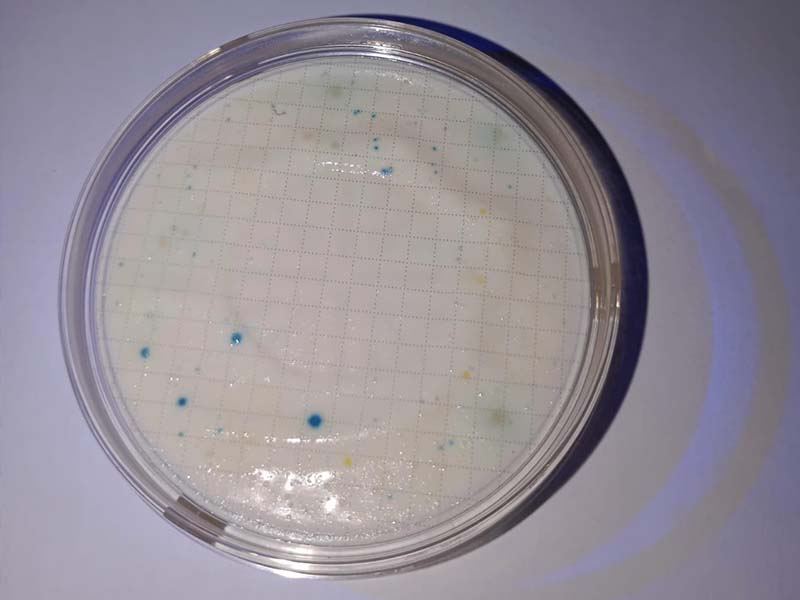
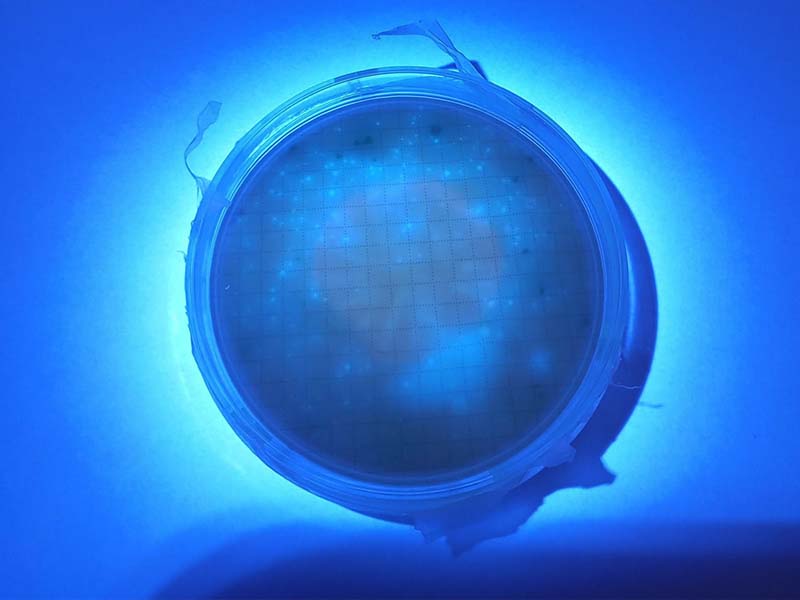

Todo en análisis de agua
Todo en análisis de agua
Todo en análisis de agua

Quiénes somos
Políticas
Contacto
Análisis, soporte y asesoría
Somos una empresa dedicada a la distribución, soporte técnico y asesoría de equipos e insumos para el análisis de agua y control de calidad en los sectores públicos, ambientales, industriales, educativos, farmacéuticos y recreativos.
Política de reemplazo
Usted puede solicitar un reemplazo de su producto sin cargo en los siguientes casos:
- El producto que recibió no es el que solicitó.
- El producto viene roto o en mal estado
- Si usted compró reactivos o soluciones y estás se encuentran derramadas o están caducadas.
Política de entrega
- Nuestro servicio de entrega sólo está disponible en Guatemala y en las principales zonas donde se tenga el servicio de entrega a domicilio.
- En caso de envíos a los departamentos y/o municipios donde no se tenga el servicio de mensajería, el cliente podrá solicitar vía correo, el envío de su mercancía al departamento o municipio más cercana a su localidad. Para esto, deberá indicar el domicilio completo, el nombre de quien recibe el paquete y el nombre del trasporte en donde desea que se envíe la mercancía. En este caso es responsabilidad del cliente monitorear el envío.
Política de cancelación
- “El cliente “solamente podrá cancelar su compra al momento de recibir la confirmación de su pedido vía correo electrónico.
NUESTRAS MARCAS

Lovibond® Tintometer es un proveedor líder de instrumentos para el análisis de agua en los sectores recreativo, ambiental e industrial, así como para la determinación precisa de diferentes tipos de agua: desde piscinas y spas; aguas potables, residuales, salobres y efluentes hasta muestras de calderas de vapor y circuitos de refrigeración.

Nantong FilterBio Membrane Co., Ltd está especializada en la fabricación de productos de microfiltración, incluida la filtración de laboratorio y la filtración industrial.
Nuestros productos
Equipos, Reactivos e Insumos de Laboratorio.
Análisis de agua
Productos nuevos
Colorimetros MD50
La serie MD50 ofrece una gama completa de fotómetros monoparámetro que satisfacen las necesidades más diversas del tratamiento del agua. Con su interfaz de usuario sin idiomas basada en iconos y animaciones, ofrece una facilidad de uso sin igual. El robusto diseño del MD50 garantiza que el instrumento pueda soportar las condiciones más duras sobre el terreno.
Medios de Cultivo MFC Y MI
MFC medio de cultivo sólido para recuento de coliformes fecales en aguas por el método de filtración de membrana.
MI medio de cultivo sólido para recuento de e.coli y coliformes fecales en aguas por el método de filtración de membrana
ESPECTROFOTOMETRO
Los instrumentos de la Serie XD son ideales para el análisis de rutina y espectral. Como verdaderos polifacéticos, los XD 7000 y XD 7500 facilitan las rutinas de trabajo, especialmente con el reconocimiento automático de métodos mediante códigos de barras, el reconocimiento automático de cubetas y más de 150 métodos preprogramados.
ELECTROQUíMICA
Conductividad, oxígeno disuelto, redox, pH, TDS: Si desea controlar estos parámetros, debe utilizar instrumentos de medición electroquímicos para una determinación fiable y rápida. Estos instrumentos pueden hacer frente a cualquier entorno directamente en el momento, son prácticos, intuitivos y fáciles de usar.
COLORIMETROS/FOTOMETROS
Los fotómetros son los más completos en el análisis del agua. Miden la concentración de una sustancia basándose en la luz que pasa a través de una muestra de agua. Los comparadores funcionan de manera similar. En la piscina, en el tratamiento de aguas residuales y en el control del agua potable en el laboratorio, en el análisis ambiental, para la vigilancia del agua de los procesos o para el control de los desinfectantes, no hay casi ningún ámbito de aplicación en el que los fotómetros no presten servicios valiosos.
SISTEMA DBO
El BD 600 es un sistema respirométrico para la determinación de la demanda bioquímica de oxígeno (DBO). Ahorre tiempo, reduzca la posibilidad de errores e interprete los datos fácilmente para tomar decisiones relativas al control de procesos de su instalación.
TURBIDIMETRO
Las partículas diminutas no sólo enturbian el agua, sino que también pueden causar daños a las personas y a los materiales. Por consiguiente, es esencial la vigilancia continua de la turbidez, especialmente para el agua potable, pero también para el agua industrial y de procesos. Esto requiere un equipo profesional que cumpla con las diversas normas y que ofrezca resultados fiables. La intensidad de la luz se mide a 90° después de que el haz de luz incidente se dispersa por las partículas causantes de la turbidez en la muestra de agua.
TERMORREACTOR
Termorreactor flexible para el acondicionamiento de muestras para la determinación fotométrica de DQO, cromo total, fosfato total, nitrógeno total y TOC. Disgregación con posibilidad de tres rangos de temperatura y tres tiempos de reacción preprogramados.
LAMINA PORTA Y CUBRE OBJETOS
Lámina de vidrio rectangular de color transparente utilizada para almacenar muestras y objetos con el fin de observarlas bajo el microscopio.
Las dimensiones típicas de un portaobjetos son de 75mm x 25mm, sin embargo pueden variar dependiendo del tipo de objeto o muestra. Los porta-objetos de microscopio se utilizan a menudo junto con un cubre-objeto, una lámina más pequeña y delgada de vidrio que se coloca sobre la muestra.
CAJAS PETRI-DISH
Las placas de petri de poliestireno son adecuadas para cultivar microorganismos en un filtro de membrana de 47 mm de diámetro. Estos platos desechables han sido diseñados para un mejor manejo en el laboratorio. Los bordes cuadrados brindan un área de agarre firme para facilitar la apertura con una mano. El borde elevado en la parte superior e inferior permite apilar los platos sin que se deslicen. La tapa de ajuste ceñido garantiza que ni la almohadilla absorbente ni el agar se sequen durante la incubación y produzcan un resultado falso.
REACTIVOS
Lovibond® es el único proveedor de productos para el análisis del agua en el mundo que fabrica por sí mismo todo tipo de reactivos, en forma de tabletas, polvo y líquido. La producción y el desarrollo de nuestros productos químicos óptimamente adaptados no sólo se basan en más de 130 años de experiencia, sino también en una calidad probada y buscada a nivel mundial, combinada con la mayor seguridad posible, una calidad de resultados controlada y una cartera adaptada a innumerables aplicaciones y parámetros
- Aluminio ECR F VARIO
- Aminoácido F10 para sílice LR VARIO
- Análisis de hidrazina con polvo
- Análisis de nitrato con polvo
- Ácido ascórbico Vario
- Ácido cítrico F10 para sílice VARIO
- Ácido cítrico F25 para sílice HR VARIO
- Ácido tartárico
- Barium Chloride
- CU1 Porphyrin F10
- CU1 Porphyrin F25
- CU2 Porphyrin F10
- CU2 Porphyrin F25
- CU3 Masking F10
- CU3 Masking F25
- Cianurato de amonio F10 VARIO
- Cianurato de amonio F5 VARIO
- Cloro libre DPD F10
- Cloro libre DPD F10 VARIO
- Cloro libre DPD F25 VARIO
- Cloro libre DPD F5 VARIO
- Cloro total DPD F10
- Cloro total DPD F10 VARIO
- Cloro total DPD F25 VARIO
- Cloro total DPD F5 VARIO
- Cromo hexavalente
- Cu1 F10 VARIO
- DQO HR
- DQO LMR
- DQO LR
- DQO MR
- DQO VLR
- Dureza, total
- FE in MO RGT 1 VARIO
- FE in MO RGT 2 VARIO
- Fosfato 3 F10 VARIO
- Hexamina F20 VARIO
- Hierro F10 VARIO
- Hierro F25 VARIO
- Hierro TPTZ F10 VARIO
- KP118-Cristales de yoduro de potasio
- KP186-S1-Indicador almidón ácido
- KP192-Z4 Ditizona
- KP216 Indicador dureza cálcica
- KP242-Reactivo coppercol 4
- KP244-Reactivo para cinc 2
- KP274-Polvo de persulfato amónico
- KP325-Tiosulfato de sodio
- KP36-MB2-Reactivo de color para molibdato
- KP475-Indicador de almidones en polvo
- KP510-Ácido cítrico
- KP534-B polvo
- KP962-Polvo de persulfato amónico
- KS170-Cartucho CM
- KS170-Cartucho CM
- KS242 Reactivo coppercol 3
- Nitrito 3 F25 VARIO
- Oxyscav 1 RGT VARIO
- Persulfato amónico P.A.
- Persulfato de potasio F10 VARIO
- Persulfato total N RGT VARIO
- Peryodato de sodio F10 VARIO
- Polvo de acondicionamiento de amonio
- Polvo de eriocromo
- Powder Pack triazol RGT F25 VARIO
- RGT ácido F10 para sílice HR VARIO
- RGT ácido F25 para sílice HR VARIO
- Reactivo B para nitrógeno nítrico Nitra X VARIO
- Reactivo COP 3 AA en polvo
- Reactivo de persulfato para CR
- Reactivo para nitrógeno total VARIO A
- Reactivo para nitrógeno total VARIO B
- Salicilato de amonio F10 VARIO
- Salicilato de amonio F5 VARIO
- Sulfato 4 F10 VARIO
- Sulfato 4 F25 VARIO
- TH1P/THLP Dureza, total polvo
- Tampón citrato de manganeso F10 VARIO
- VARIO Monochlor F Rgt
- VARIO Nitri 3 F10
- VARIO Nitri NT-2 F10
Filtros y membranas
Filtros de jeringa
Filtros de jeringa y membranas para la eliminación de materiales interferentes y partículas finas antes de la inyección; se incluyen filtros con y sin jeringas; adecuados para muestras acuosas y acuosas-orgánicas.
El filtro de jeringa tiene 3 tipos de diámetros, 13 mm, 25 mm.
Materiales MCE, NYLON PTFE, PVDF, CA, OES, RC, PP.
Filtros de membrana
Cartuchos de membrana finos y precortados para una filtración rápida y de alto rendimiento de muestras de líquidos y gases. Discos con rejilla y sin rejilla. Varios materiales, incluidos éster de celulosa mixta, policarbonato, PTFE, NYLON y PVDF. Para monitorización ambiental/investigación analítica.
Diametro de 13 mm – 142 mm. Tamaño de poro 0,22 μm, 0,45 μm